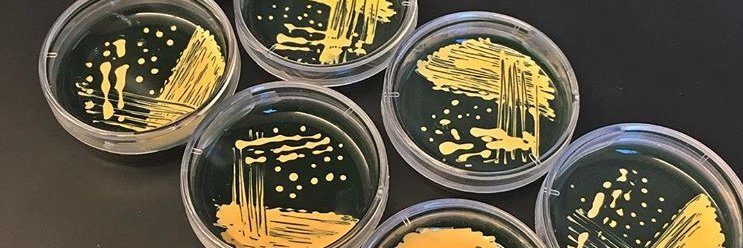
Alix Purdy banner

Alix Purdy
648 posts

Alix Purdy
@ae_purdy
microbiologist with a background in infectious disease and marine biology studying Vibrios in collaboration with talented undergrads at Amherst College.









Just surprise sat in on @ae_purdy’s Microbiology class and it felt like going home 😍

My lab and I are heartbroken by the loss of Dr. Gary Heussler, who passed away unexpectedly last week. Gary was a beacon of positivity and humor in our lab, with infectious enthusiasm for microbiology and mentoring. He was a cherished part of our community and is deeply missed.

My lab and I are heartbroken by the loss of Dr. Gary Heussler, who passed away unexpectedly last week. Gary was a beacon of positivity and humor in our lab, with infectious enthusiasm for microbiology and mentoring. He was a cherished part of our community and is deeply missed.






The MBL is proud to announce the 2022 Whitman Center Fellows! A diverse group of 28 scientists from universities and research institutes from around the world have been named Whitman Center Fellows. Meet the scientists! 👇👇👇 mbl.edu/news/mbl-annou…





Did you know more than 450 oral abstract presentation slots are available at #ASMicrobe? That means you have a 1-in-7 chance of being selected for an oral presentation. Make sure your science is seen. Submit your abstract by Jan. 19! asm.social/ni
